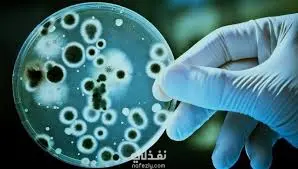

التدريس وتلخيص محاضرات
تفاصيل العمل
السلام عليكم مهارتي في التلخيص والتبسيط من اهتمامي وتعمقي في الدراسة في مختلف المجالات، وأمتلك خاصة خلفية علمية قوية في مجالي التكنولوجيا الحيوية، وعملت على شرحها لطلاب في نهاية المرحلة الإبتدائية وبداية الإعدادية وحصلت معهم على المركز الأول في مسابقة للطلاب وتم التقييم على المحتوى والقوة في العرض والتفاصيل الدقيقة. هوايتي التعلم وتعليم العلوم وتبسيطها لجميع المراحل العمرية إذا كنت تحتاج للمساعدة في يمكنني مساعدتك سواء في المناهج الدراسية ما قبل الجامعة أو الجامعية أو الدراسات العليا. الساعة مقابل 5$ ويسعدني العمل معكم ومساعدتكم.
مهارات العمل
بطاقة العمل
طلب عمل مماثل